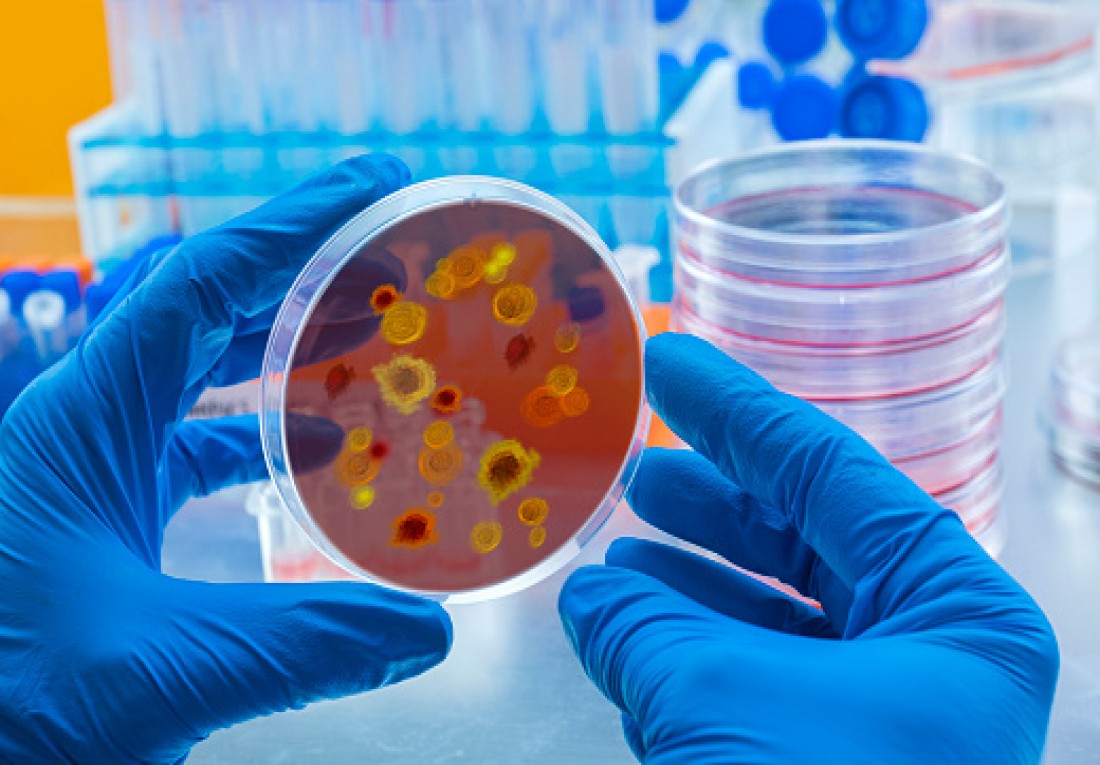

দিন দিন ডিপ্রেশন বেড়ে যাচ্ছে কি
বর্তমান সময়ে আমাদের জীবনের অন্যতম বড় সমস্যা ডিপ্রেশন। আমাদের পরিবার, বন্ধু-বান্ধব, এমনকী ন ...
Health experience | Write here | Write and share your health experience to help community.
![]() Fahima Akter
Wednesday, September 15, 2021
Fahima Akter
Wednesday, September 15, 2021
সোয়াইন ফ্লু, H1N1 ফ্লু নামেও পরিচিত। সোয়াইন ফ্লু একটি সাধারণ শ্বাসযন্ত্রের রোগ। টেকনিক্যালি, সোয়াইন ফ্লু একটি রোগ যা শুকরকে প্রভাবিত করে। কিন্তু একটি বিশেষ ধরনের ইনফ্লুয়েঞ্জা, যা H1N1 মানুষকে প্রভাবিত করে। এটি একটি অত্যন্ত সংক্রামক রোগ যা মানুষের সংস্পর্শের মাধ্যমে ছড়াতে পারে। যদি কোন সুস্থ ব্যক্তি H1N1 সংক্রামিত ব্যক্তিকে স্পর্শ করে তাহলে সেই ব্যক্তির সোয়াইন ফ্লু রোগে আক্রান্ত হওয়ার সম্ভবনা থাকে । বিশ্ব স্বাস্থ্য সংস্থা সোয়াইন ফ্লুকে বিশ্বব্যাপী মহামারী হিসেবে ঘোষণা করেছে। রোগের সাধারণ লক্ষণ হলো জ্বর, সর্দি, কাশি, ক্লান্তি, ডায়রিয়া, বমি বমি ভাব, শরীরে ব্যাথা, চোখে পানি এবং গলা ব্যাথা।
সোয়াইন ফ্লু একটি সংক্রমণ যা সাধারণত একটি ভাইরাস দ্বারা সৃষ্ট হয়। সোয়াইন ফ্লু থেকে নিজেকে রক্ষা করার জন্য এখনো কোন ভ্যাকসিন পাওয়া যায় নি। সেইসাথে ইনফ্লুয়েঞ্জার চিকিৎসার জন্য প্রচুর ঔষধ পাওয়া যায়। সোয়াইন ফ্লু সাধারণত ৫৫ বছর বয়সী এবং ৫ বছরের কম বয়সী শিশুদের আক্রমণ করে। কারণ এই বয়সী মানুষদের রোগ প্রতিরোধ ক্ষমতা উভয় ক্ষেত্রেই দুর্বল। এই বয়সের মানুষেরা সোয়াইন ফ্লু ছাড়াও দীর্ঘস্থায়ী অসুস্থতা যেমন- হাঁপানি, কার্ডিও ভাস্কুলার রোগ এবং ডায়াবেটিসে ভুগতে পারে।
সোয়াইন ফ্লু সাধারণত ভাইরাস দ্বারা সৃষ্ট হয়। এটি সাধারণত টাইপ H1N1 ইনফ্লুয়েঞ্জা নামেও পরিচিত। H1N1 হলো সবচেয়ে সাধারণ উপপ্রকার যা বেশিরভাগ মানুষের মধ্যে ছড়িয়ে পড়ে। এটি কাশি, হাঁচি, সরাসরি যোগাযোগের আকারে সংক্রমণ ঘটায়। H1N1 সোয়াইন ফ্লু মানুষের মধ্যে যেটি পাওয়া যায় তার থেকে আলাদা।
যেহেতু মানবদেহে ভাইরাসের এন্টিবডি নেই। তাই মানুষ যখন অসুস্থ হয়ে পড়ে তখন যদি তারা এমন ব্যক্তির সংস্পর্শে আসে যার ইতিমধ্যেই সোয়াইন ফ্লু হয়েছে, সেই সুস্থ ব্যক্তিরও তখন সোয়াইন ফ্লু হওয়ার সম্ভবনা থাকে। অনেক মানুষই ভুল ভাবে বিশ্বাস করে যে মানুষ শুয়োর থেকে বা আক্রান্ত শুয়োরের মাংস খেয়ে সোয়াইন ফ্লু ভোগে। এটা একেবারেই ভুল ধারণা। H1N1 ভাইরাস সাধারণত অন্যান্য মৌসুমী সংক্রমণ বা ইনফ্লুয়েঞ্জার মতোই ছড়িয়ে পড়ে। আক্রান্ত ব্যক্তির হাঁচি, কাশি বা থুতুর মাধ্যমে চোখ, নাক এবং/অথবা মুখ দিয়ে সোয়াইন ফ্লুতে আক্রান্ত হওয়ার সম্ভবনা থাকে। এমনকি সংক্রামিত ব্যক্তির সাথে কাপড় ভাগ করলে ভাইরাসটি সুস্থ শরীরে স্থানান্তরিত হতে পারে।
সোয়াইন ফ্লুতে স্থানান্তরের প্রধান উৎস বায়ু যা এটিকে অত্যন্ত সংক্রামক করে তোলে। সোয়াইন ফ্লুর লক্ষণগুলি নিয়মিত ফ্লুর মতোই। অতএব, যদি কোন ব্যক্তি নিম্নলিখিত লক্ষণগুলির মধ্যে কোনটি অনুভব করে তবে তার অবশ্যই ডাক্তারের সাথে পরামর্শ করা উচিত। ডব্লিউএইচওর মতে, সোয়াইন ফ্লু এবং নিয়মিত ফ্লুর মধ্যে প্রধান পার্থক্য হলো- সোয়াইন ফ্লু অনেক বেশি সংক্রামক এবং দ্রুত বেশি মানুষকে প্রভাবিত করতে পারে। যেহেতু H1N1 ইনফ্লুয়েঞ্জা মোটামুটি নতুন। মানবদেহ এখনও এই রোগ থেকে নিজেকে রক্ষা করার জন্য যথেষ্ট প্রতিরোধী নয় এবং তাই ভাইরাসের বিরুদ্ধে প্রতিরোধ ক্ষমতা নেই।সোয়াইন ফ্লুর কিছু সাধারণ লক্ষণ হল:
১/ জ্বর: জ্বর ১০০ ডিগ্রি সেলসিয়াস পর্যন্ত যেতে পারে। কারণ মানবদেহ সোয়াইন ফ্লু এর সাথে যে ভাইরাস নিয়ে আসে তার বিরুদ্ধে প্রতিরোধ করার জন্য ডিজাইন করা হয়নি। যদি কোন ব্যক্তির জ্বর ২ ঘন্টার বেশি সময় ধরে দীর্ঘায়িত হয়, তাহলে চিকিৎসক তাকে একবার সোয়াইন ফ্লু পরীক্ষা করার পরামর্শ দিয়ে থাকে।
২/ মাথাব্যাথা: সোয়াইন ফ্লুর আরেকটি প্রধান লক্ষণ হলো যদি কোন ব্যক্তি সোয়াইন ফ্লুতে আক্রান্ত হয়, তাহলে তার গুরুতর মাথাব্যাথা হতে পারে। যা ঔষধ খাওয়ার পরেও অদৃশ্য হয় না।
৩/ ডায়রিয়া: এটি এমন একটি লক্ষণ যা নিয়মিত ফ্লু থেকে সোয়াইন ফ্লুকে আলাদা করে। যদি কারো ডায়রিয়ার সাথে উচ্চ জ্বর থাকে, তাহলে সম্ভবত তার সোয়াইন ফ্লু হওয়ার সম্ভাবনা রয়েছে।
৪/ কাশি এবং হাঁচি: কাশি এবং হাঁচি সোয়াইন ফ্লু হওয়ার সবচেয়ে সাধারণ লক্ষণ। কারণ এটি অত্যন্ত সংক্রামক। যদি কোন ব্যক্তি আক্রান্ত ব্যক্তির সংস্পর্শে আসার পরই কাশি এবং হাঁচি অনুভব করেন, তাহলে তারও সোয়াইন ফ্লু হতে পারে।
৫/ ক্লান্তি এবং শরীরের ব্যাথা: ক্লান্তি এবং শরীরের ব্যাথা শরীরের প্রতিরোধ ক্ষমতা চ্যালেঞ্জের একটি সাধারণ উপায়। কেননা মানুষ যখন তার শরীরে ক্লান্তি বোধ করে তখন তার রোগ প্রতিরোধ ক্ষমতা অনেক কমে যায়। রোগ প্রতিরোধ ক্ষমতা কমে যাওয়ার ফলে সোয়াইন ফ্লু হওয়ার সম্ভবনা বেড়ে যায়।
সোয়াইন ফ্লু প্রতিরোধের কিছু বিষয়ের প্রতি নজর দেওয়া উচিত। যেমন-
১/ যতটা সম্ভব জনাকীর্ণ স্থান এড়িয়ে চলা : যেহেতু ফ্লু মৌসুম চলছে এবং সোয়াইন ফ্লু এই সময়ে দ্রুত ছড়িয়ে পড়ে, তাই যতটা সম্ভব জনাকীর্ণ স্থান এড়িয়ে চলাই ভালো।
২/ হাত ভালোভাবে ধুয়ে পরিষ্কার রাখতে হবে : যখনই কোন ব্যক্তি জনসাধারণের সম্পদ স্পর্শ করেন তখন তার হাত ধোয়া নিশ্চিত করতে হবে। যেহেতু সোয়াইন ফ্লু সরাসরি বা পরোক্ষ যোগাযোগের মাধ্যমে ছড়ায়, তাই এটি একটি গুরুত্বপূর্ণ পদক্ষেপ।
৩/ যদি কেউ সোয়াইন ফ্লুর অনুরূপ উপসর্গ দেখে থাকেন তার অবশ্যই ডাক্তারের সাথে যোগাযোগ করা উচিত। সোয়াইন ফ্লু এর লক্ষণগুলি শনাক্ত করার সাথে সাথেই ডাক্তারের পরামর্শ নিতে হবে।
৪/ যদি কোনো পাবলিক প্লেসে যাওয়ার প্রয়োজন হয় তাহলে সতর্কতা অবলম্বন করতে হবে। সব সময় হ্যান্ড স্যানিটাইজার এবং মাস্ক সঙ্গে রাখতে হবে। এটি নিজেকে রক্ষা করতে সাহায্য করবে।
৫/ সক্রিয় থাকার চেষ্টা করতে হবে। ব্যায়াম রোগ প্রতিরোধ ক্ষমতা তৈরি করতে সাহায্য করে। ফ্লু মৌসুমে শক্তিশালী রোগ প্রতিরোধ ক্ষমতা গড়ে তুলতে যথেষ্ট সক্রিয় থাকতে হবে এবং নিয়মিত ব্যায়াম করতে হবে।
৬/ টিকা নিতে হবে : যদি কেউ একবার সোয়াইন ফ্লু এর টিকা নিয়ে থাকে, তাহলে এটা মনে করা যাবে না যে সে নিরাপদ। নিয়মিত মেডিকেল চেকআপ এবং টিকা দিয়ে আপ টু ডেট থাকতে হবে ।
৭/ হাইড্রেটেড থাকতে হবে : প্রতিদিন ন্যূনতম ৮-১০ গ্লাস পানি পান করা অপরিহার্য। কারণ হাইড্রেটেড বিষাক্ত পদার্থ দূর করতে এবং রোগ প্রতিরোধ ক্ষমতা বজায় রাখতে সাহায্য করে।
৮/ অ্যালকোহল এবং কার্বোনেটেড পানীয় এড়িয়ে চলতে হবে : অ্যালকোহল এবং কার্বনেটেড পানীয়ের মতো পদার্থগুলি মানুষের রোগ প্রতিরোধ ক্ষমতাকে মারাত্মকভাবে প্রভাবিত করতে পারে। কারণ সেগুলি মানুষের রোগ প্রতিরোধ ক্ষমতার কোষকে দুর্বল করে দেয়। এগুলি সংক্রমণের বিরুদ্ধে মানুষের প্রতিরোধ ক্ষমতাকেও হ্রাস করে থাকে ।
একবার কোন ব্যক্তি সোয়াইন ফ্লুতে শনাক্ত হয়ে গেলে, রোগীর অবস্থা কতটা খারাপ তার উপর নির্ভর করে একটি ভালো চিকিৎসার পরিকল্পনা করতে হবে। সেইসাথে প্রচুর পরিমাণে অ্যান্টিবায়োটিক, কাশি উপশমকারী এবং ব্যাথানাশক ঔষধ অন্তর্ভুক্ত রাখতে হবে। অন্যান্য রোগের মতো, প্রচুর বিশ্রাম নেওয়াও একটি গুরুত্বপূর্ণ বিষয়। রোগীদের ভাইরাসের বিস্তার রোধে অন্যান্য মানুষের সাথে যোগাযোগ সীমিত করে দিতে হবে।
সোয়াইন ফ্লুর চিকিৎসার জন্য সর্বাধিক ব্যবহৃত কিছু ঔষধ হলো তামিফ্লু এবং রেলেনজার মতো অ্যান্টিভাইরাল ঔষধ। যার শক্তিশালী এজেন্ট রয়েছে যা ভাইরাল কোষগুলিকে লক্ষ্য করে এবং তাদের নির্মূল করে। পুনরুদ্ধারের সময় রোগীদের অবশ্যই একটি গুরুত্বপূর্ণ সতর্কতা অবলম্বন করতে হবে। তা হলো বাইরের ক্রিয়াকলাপকেও সীমাবদ্ধ করা। ভিটামিন এবং পুষ্টির পরিমাণ বৃদ্ধি করা উচিত যা রোগ প্রতিরোধ ক্ষমতা বাড়ায়।
এছাড়াও কিছু ঘরোয়া প্রতিকার রয়েছে যা সোয়াইন ফ্লু প্রতিরোধে সহায়ক হতে পারে। প্রতিদিন সকালে তুলসী (তুলসী) খাওয়া। তুলসী মানুষকে উপসর্গ থেকে মুক্তি দিতে পারে। রসুন, কর্পূর, অ্যালোভেরার মতো প্রাকৃতিক ফ্লু উপশমকারীও অনেক সাহায্য করে থাকে।
SHARE THIS
Share
sunburn antiseptic polycystic ovary syndrome peritonitis nausea and vomiting helicobacter pylori infection calcium and vitamin d supplement injuries sleep disorder swine flu prostate cancer multiple sclerosis cholera neurosyphilis dandruff hypertension motion sickness strains skin infection bone marrow transplantation dizziness irritability spine in old age acute myocardial infarction hypothyroidism bladder abdominal pain hypotension colds hiv infection colon cancer vaginal itching mania bipolar disorder sore throat


বর্তমান সময়ে আমাদের জীবনের অন্যতম বড় সমস্যা ডিপ্রেশন। আমাদের পরিবার, বন্ধু-বান্ধব, এমনকী ন ...
1 Like

স্বাভাবিক ডেলিভারি ঝুঁকিপূর্ণ হলে মা ও শিশুর সুস্থতার স্বার্থে সিজার পদ্ধতিতে ডেলিভারির প্ ...
2 Like


অ্যালকোহল এমন একটা পানীয় যা দেখলেই পান করতে মন চায়। আগের দিনে অ্যালকোহল জলের বিকল্প হিসেব ...
2 Like

নাক বন্ধে নাকের ড্রপ ব্যবহারে কি কোনো পার্শ্বপ্রতিক্রিয়া আছে?উত্তর: কিছু কিছু নাকের ...
0 Like

জ্বর কোনো রোগ নয়, রোগের উপসর্গ। অনেক জ্বরেই কোনো অ্যান্টিবায়োটিকের প্রয়োজন হয় না। জ্বর হলে ...
1 Like

হোমিওপ্যাথি একটি লক্ষণ ভিত্তিক চিকিৎসা বিজ্ঞান । মনেরাখতে হবে যে, রোগের লক্ষণগুলোই রোগের প ...
0 Like

হোমিওপ্যাথি একটি লক্ষণ ভিত্তিক চিকিৎসা বিজ্ঞান । মনেরাখতে হবে যে,রোগের লক্ষণগুলোই রোগের পর ...
0 Like


অ্যাসিডিটি মানেই পেটের সর্বনাশ! কখনও বুকজ্বালা, কখনও ঢেঁকুর আবার কখনও বায়ুর চাপ। এরপর তেলজ ...
0 Like
New to Welfarebd? Sign up
Subscribe to our newsletter & stay updated
0